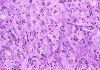

| A 13 year-old boy with three years history of
seizure. September, 2004. Case 409-1 Home Page |
Chimène Kesserwan, M.D., Kar-Ming Fung, M.D., Ph.D. Last Update September 30, 2004.
Department of Pathology, University of Oklahoma Health Science Center, Oklahoma City, Oklahoma.
Clinical information: A 13-year-old boy presented with increasingly frequent and severe simple partial seizures since age 10 years. There was no history of prematurity, perinatal injury, febrile seizure, trauma, meningitis, encephalitis or developmental delay. Neurological and visual field examination were normal. Scalp EEGs showed no epileptiform activity. Head MRI showed a 2 cm plaque like intra-axial cortical lesion in the right frontal lobe with features suggestive of a vascular malformation. No calcification was identified on CT scan. The lesion was excised. The patient remains seizure-free without antiepileptic drugs 5 years after.
 |
 |
 |
|
 |
 |
| A | B | C | D | E | F |
 |
 |
 |
 |
||
| G | H | I | J |
Pathology of the case:
Gross pathology: In the cortex, there was a 2.0 cm wide poorly demarcated cortex that appeared unusually firm, pale, and thickened.
Histopathology: On histologic examination, the cortex lesion (C-L in Panel A) appear fibrous and vascular. It is well demarcated from the white matter (W in Panel A). The cortical lesion respects the grey-white junction and the interface is smooth. These features are better appreciated on Masson's trichrome stain. While one side of the gyrus is replaced by the lesion (C-L in Panel E), normal cortex is present on the other side of the gyrus (C-N in Panel E). White matter (W in Panel E) and the normal cortex (C-N in Panel E) carry a pink hue on Masson's trichrome.he fibrous lesion (C-L in Panel E) does not carry much of this pink hue. The lesion essentially follow the shape of the gyrus with some cortical thickening (Panel F). On higher magnification, the cortical lesion is highly vascular (Panel B, C, and G). In between the fibrous vascular component, there are entrapped islands of cortical tissue (Panel D, H, and I ). There is a general lack of pleomorphism and mitotic activities in the lesion.
|
DIAGNOSIS: Meningioangiomatosis |
Discussion: General Information Pathology Differential diagnosis Pathogenesis
General Information
Meningioangiomatosis was first described in 1915 by Bassoe and Nuzum 1 and thereafter named in 1937 by Worster-Drought et al. 2 It is a rare, benign, focal lesion of leptomeninges and the underlying cerebral cortex, characterized by leptomeningeal and meningiovascular proliferation 3. It is considered by some authors to represent a possible hamartomatous lesion consisting of an intracortical plaque-like proliferation of meningothelial cells, microvasculature and fibroblast-like cells 4.
Meningiomatosis usually affects children and young adults. The age of patients, however, ranges from 9 months to 70 years. As per the study by Wiebe et al., MA associated with NF II are much more often found as incidental findings than sporadic cases that are not associated with NF2. A patient with meningiomatosis should, therefore, be worked up for NF2.
A significant number of patients remain asymptomatic and the lesions are identified incidentally on autopsy. The literature suggests higher occurrence in males and in the right hemisphere. Seizure and/or headache are the most common clinical presentation. Facial pain, lower cranial nerve palsies can also occur 3. There is often a progressive difficulty in controlling the partial seizures. A fatal subarachnoid haemorrhage from right frontal-mesial MA has been reported and described in the setting of atypical clinical features 5. About 70% of MA are found in the frontotemporal region. Other locations include the third ventricle, thalamus and cerebral peduncles, and the brain stem 3, 6. The lesions may be single or diffuse and are often associated with neurofibromatosis type 2 (NF2) 3, 5.
MA lack specific imaging characteristics on CT and MRI scans. CT scans usually reveals leptomeningeal calcifications with little or no contrast enhancement. MRI reveals a cortical lesion that is isointense or hypointense on T1-weighed images. Cysts may be present The lesions are heterogeneous on T2-weighed images surrounded by an area of increased signal intensity. Multiple lesions can occur 7.
Macroscopically, MA often occur as a firm, plaque-like, thickening of the cortex and the overall morphology follows the shape of the cerebral cortex. The lesion is sharply demarcated. Larger lesions can be over 5 cm in greatest dimension. Multiple lesions can occur. The white matter is often respected and not intruded by the lesion. In contrast to meningiomas, they are not dural based. In rare occasions, they occur in the deep grey matter and in the brain stem.
Histologically, the salient feature is a disorganized lesion featured by perivascular meningothelial cells intermingled with a fine, rich vascular network. Although each lesion is unique, increased cortical vascularity and perivascular cellular proliferation are constant findings. Irregularly branched blood vessels extending into the gray matter from the meningeal surface are surrounded by a concentric arrangement of proliferating spindle-formed cells .The overall structure can occur as nodules, whorls, or bands. Islands of cortical tissue with gliosis are often trapped within the lesion. The ratio between meningothelial component and vascular component varies substantially. There are lesions predominantly composed of vascular component or meningothelial component 3. A schwannian component can also occur. There are also cortical meningovascular fibroblastic proliferation and leptomeningeal calcifications that range from faint psammomatous calcification to dense osteoid. Residual neurons entrapped within the lesion may contain neurofibrillary tangles with ultrastructural and immunostaining properties identical to those seen in Alzheimer's disease but there is no deposition of amyloid Ab.
Immunohistochemistry is not very helpful in diagnosis. The proliferation is low and a low Ki67 labeling index can usually be documented. Vimentin is the most constantly expressed antigen but does not really help in arriving the diagnosis. The cells are variably immunoreactive for epithelial membrane antigen (EMA), S100 protein, Leu-7 and glial fibrillary acidic progein.
Ultrastructurally, the proliferating cells are composed of elongated heterochromatin-rich nuclei and slender cytoplasm-containing microfilaments, occasionally associated with desmosomal junctions and basal lamina like structures.
Differential diagnosis
When it is presented in the classic clinical settings and an adequate amount of tissue is available for examination, the diagnosis of MA should not pose too much of a trouble. The major differential diagnoses include meningioma with brain invasion, particularly the en plaque form, and vascular malformation. Others include glial or glial-neuronal tumors with desmoplastic changes.
Meningioma with brain invasion can pose a pose a problem particularly if the imaging characteristics or macroscopic features are not known. Most meningiomas form a mass and do not follow the shape of the cortex. Vascular proliferation associated with vascular proliferation is not an extensive feature but may be focally present. Infiltration of meningioma into the brain parenchyma is usually associated with destruction of pia mater or the Virchow-Robin space. The invading meningioma occurs as finger like protrusion into the brain parenchyma. On the other hand, gliotic brain parenchymal tissue are trapped as small islands in between the vascular and meningothelial proliferation in MA. The area of invasion is more often to be focal then extensive as compared to MA. In higher grade meningiomas, namely atypical meningiomas and anaplastic meningiomas, there is nuclear pleomorphism. MA, in contrast, has no nuclear pleomorphism. Mitotic figure and high proliferating (Ki67) labeling index should not be seen in MA but can be seen in meningiomas.
Giangaspero et al. 10 reported two cases of MA associated with meningioma and they underscored the features distinguishing this combination from meningiomas invading the brain tissue. Extension of meningiomas along the vessels in the Virchow-Robin spaces does not technically represent parenchymal invasion but may indicate an increased probability of recurrence. True invasion is present when neoplastic cells break through the pia mater to involve the underlying cortex and encircle islands of heavily gliotic tissue. Such a condition may be closely simulated by MA in which gliotic cortical tissue is encircled by meningothelial cells and fibroblasts characteristically disposed around blood vessels. Moreover, residual cortical neurons frequently contain neurofibrillary tangles indistinguishable from those seen in Alzheimer's disease. Although neurofibrillary tangles have been observed in the cortex of various conditions not related to Alzheimer's disease, they have not been reported in cerebral cortex invaded by meningiomas 10. The presence of neurofibrillary tangles and profuse cortical microvasculature would support a diagnosis of MA. Lack of meningothelial atypia, necrosis, or cortical destruction favor MA.
Glial neoplasm that invades into the leptomeninges may generate a pattern that remotely simulates MA. The distinction is usually not difficult on morphological grounds and by immunohistochemistry. Desmoplastic infantile ganglioglioma and desmoplastic infantile astrycytomas can histologically suggest MA to the novice. However, they all occurs as mass lesions but not as en plaque lesions that follows the shape of the corted.
Meningiomas are featured by small sized vessels, their uniform distribution, lack of hemorrhage, normal intervening tissue, associated meningothelial and fibroblastic proliferation, and superficial location should preclude diagnosis of a vascular tumor or malformation.
The histogenesis and pathogenesis remain controversial, has been debated for a long time, yet the histology remains unique. The NF2 gene and its contiguous genes probably play a role in its pathogenesis. Takeshima et al. 8, reported a case of MA occurring in a young male without neurofibromatosis. However, loss of heterozygosity (LOH) on microsatellite markers flaning the NF2 gene was identified in the spindle cells of the lesion.
Hamartomatous origin: The histopathology and topology of MA suggest that they are hamartomas that has undergone degenerative changes. Biologically, MA is a slow-growing lesion with low Ki67 labeling index 9.These features are also compatible with the hamatomatous etiology.
Neoplastic meningothelial origin: Another possibility is that MA is a primary meningothelial cell proliferation and a variant of meningioma with the topology similar to en plaque meningioma. Meningioma associated with MA has been described and suggests that MA is primarily a proliferative meningothelial lesion 10, 11, 12. The meningioma–MA association supports the notion that MA is primarily a meningothelial lesion that occasionally may proliferate to produce a solid mass of a meningioma. The association of MA and meningioma. MA may accompany childhood meningiomas more often than is generally appreciated 11, 12. The cells in MA have immunohistochemical profile and ultrastructural features of meningothelial cells 13, 14. Sinkre P. et al 15 reported a case of juxtaposed atypical meningioma and MA in an 8-year-old boy with no clinical stigmata or family history of neurofibromatosis. They studied the proliferative activity and genetic changes in the two lesions in an attempt to define their biologic and pathogenetic relationships. There was loss of the NF2 locus (22q12) in both the meningioma and MA raising doubt about the presumed hamartomatous nature of MA. Both the meningioma and MA might have arose from the same clonal process, with the meningioma probably undergoing additional, but undefined, genetic alterations that confer upon it a more proliferative potential. A study by Halper et al 19 also suggest a meningothelial origin.
Pluripotent stem cell differentiation: Wiebe et al. 3, based on review of hematoxylin-eosin stain and immunohistochemistry, suggests that pluripotent cells may differentiate into the various cell types found in MA.
Myofibroblastic/fibroblastic origin: Paulus 16 have suggested a fibroblastic (probably perivascular) origin on the basis of association with procollagen I and III, lack of collagen IV, and vimentin immunoreactivity. Immunoreactivity for smooth muscle actin in the spindle cells of MA suggest a myofibroblastic origin 17, 18.
Reference:
Bassoe E, Nuzum F. Report of a case of central and peripheral neurofibromatosis. J Nerv Ment Dis 1915; 42: 785–96.
Worster-Drought C, Dickson WEC, McMenemey WH. Multiple meningial and perineural tumors with analogous changes in the glia and ependyma (neurofibromatosis). Brain 1937; 60: 85–117.
Wiebe S, Munoz DG, Smith S, Lee DH. Meningioangiomatosis: a comprehensive analysis of clinical and laboratory features. Brain 1999; 122: 709–26.
Iezza G, Loh C, Lanman TH, Yong WH. 33-year-old male with a frontal lobe mass. Brain Pathology 13:643-5, 2003.
Savargaonkar P, Chen S, Bhuiya T, Valderrama E, Bloom T, Farmer PM. Meningioangiomatosis: report of three cases and review of the literature. Annals of Clinical & Laboratory Science. 33:115-8, 2003.
Kollias SS, Crone KR, Ball WS Jr, Prenger EC, Ballard ET. Meningioangiomatosis of the brain stem: case report. J Neurosurg 1994;80:732-735
Park MS, Suh DC, Choi WS, Lee SY, Kang GH. Multifocal meningioangiomatosis: a report of two cases. American Journal of Neuroradiology 20:677-80, 1999.
Takeshima Y, Amatya VJ, Nakayori F, Nakano T, Sugiyama K, Inai K. Meningioangiomatosis occurring in a young male without neurofibromatosis: with special reference to its histogenesis and loss of heterozygosity in the NF2 gene region. American Journal of Surgical Pathology 26:125-9, 2002.
Prayson RA. Meningioangiomatosis. A clinicopathologic study including MIB1 immunoreactivity. Archives of Pathology & Laboratory Medicine 119:1061-4, 1995.
Giangaspero F, Guiducci A, Lenz FA, Mastronardi L, Burger PC. Meningioma with meningioangiomatosis: a condition mimicking invasive meningiomas in children and young adults. Am J Surg Pathol 1999; 23: 827–75.
Mut M, Soylemezoglu F, Firat MM, Palaoglu S. Intraparenchymal meningioma originating from underling meningioangiomatosis: case report and review of literature. J Neurosurg 2000; 92: 706–10.
Blumenthal D, Berho M, Bloomfield S, Schochet SS Jr, Kaufman HH. Childhood meningioma associated with meningioangiomatosis: case report. J Neurosurg 1993; 78: 287.
Kunishio K, Yamamoto Y, Sunami N, Satoh T, Asari S, Yoshino T, Ohtuki Y. Histopathologic investigation of a case of meningioangiomatosis not associated with von Recklinghausen's disease. Surg Neurol 1987; 27: 575–9.
Fujimoto K, Nikaidoh Y, Yuasa T, Nagata K, Ida Y, Fujioka M, Ohnishi H, Kurokawa S. Meningioangiomatosis not associated with von Recklinghausen's disease--case report. Neurologia Medico-Chirurgica. 33:651-5, 1993.
Sinkre P, Perry A, Cai D, Raghavan R, Watson M, Wilson K, Barton Rogers B. Deletion of the NF2 region in both meningioma and juxtaposed meningioangiomatosis: case report supporting a neoplastic relationship. Pediatric & Developmental Patholog 2001; 4:568-72.
Paulus W, Peiffer J, Roggendorf W, Schuppan D. Meningio-angiomatosis. Path Res Pract 1989; 184: 446–52
Chakrabarty A, Franks AJ. Meningioangiomatosis: a case report and review of the literature. Br J Neurosurg 1999; 13: 167–73.
Izycka-Swieszewska E, Rzepko R, Kopczynski S, Franc Z, Szurowska E, Borowska-Lehman J. Meningioangiomatosis with a predominant fibrocalcifying component. Neuropathology 2000; 1: 44–8.
Halper J, Scheithauer BW, Okazaki H, Laws ER Jr. Meningio-angiomatosis: a report of six cases with special reference to the occurrence of neurofibrillary tangles. J Neuropathol Exp Neurol 1986; 45: 426–46.